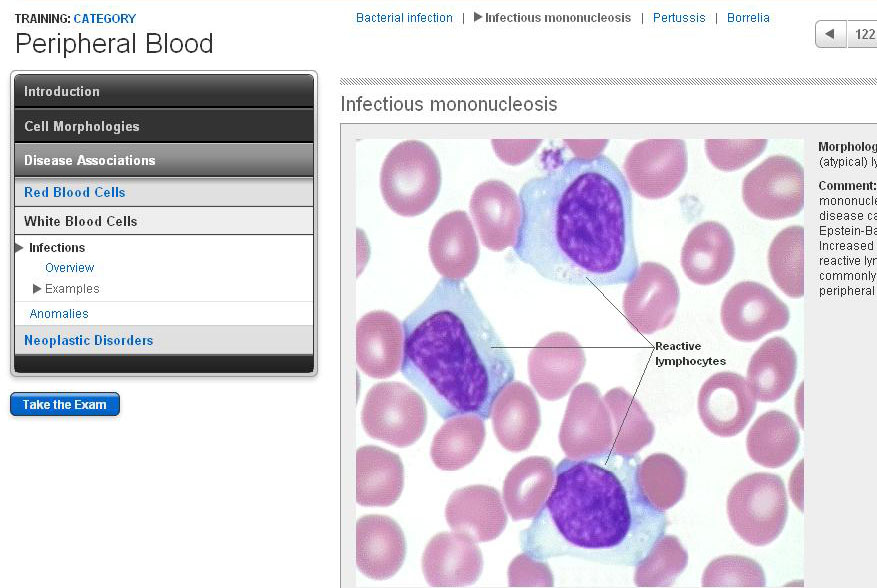

Peripheral Blood
Instructor:
Brent L. Wood, MD, PhD; Janet D. Curtis, BS, MT(ASCP); Joyce A. Behrens, MS, MT(ASCP); Adam R. Orkand, BA; Michael L. Astion, MD, PhD
Contact Hours:
2.0
Date:
January 01, 2025 - December 31, 2026
Description:
Peripheral blood smear preparation and interpretation.
Learning Objectives:
- Describe the steps necessary for the preparation of a Wright-stained peripheral blood smear and its proper microscopic evaluation.
- Identify the sequence of cell types encountered during normal maturation of myeloid, erythroid, and megakaryocytic cells in the marrow.
- Recognize and name the normal and abnormal forms of neutrophils, erythrocytes, lymphocytes, macrophages, and platelets using proper medical terminology.
- Correlate single morphologic abnormalities seen in any of the above cell lineages to one or more specific disease states.
- Integrate combinations of morphologic abnormalities involving one or more cell lineages to suggest a diagnosis of a disease state.